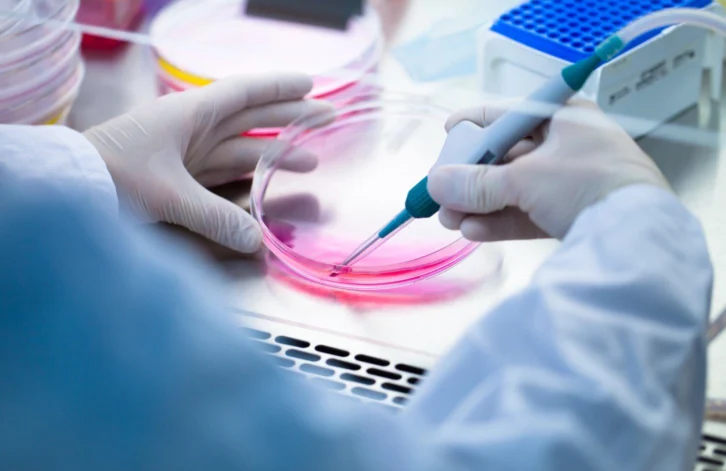

BSF Enterprise, a London-listed biotech with operations in Newcastle, is in the process of raising £15m in equity funding to support the commercialisation of its engineered tissue technology.
Founded in 2018, BSF Enterprise specialises in tissue-engineered materials and has notably been involved in lab-grown meat development as well as deploying manufactured tissue across a variety of use cases such as for leather, human corneal repair and more.
With the new funding, set to come from Blackstone Mercantile Group, the company will look to accelerate the commercialisation of these use cases. This will include a commercial launch of Elemental X, the firm’s proprietary platform for bio-based materials with integrated bioengineered cellular structures for making leather.
A small portion of the new funding has also been earmarked for Kerato, a subsidiary of the firm which leads on its corneal repair technology. Approximately £500,000 has been designated for the subsidiary, with additional funding set to come via a grant from the Canadian government.
“We are hugely excited by the potential Blackstone Mercantile Group’s investment provides to BSF’s subsidiary companies,” commented Che Connon, chief executive of BSF Enterprises.
“The funds will accelerate the commercial and technological roadmaps of LGL, Kerato and 3DBT and will support their further independent fundraising activities during 2026.
“In addition, they provide the resources to allow BSF to deliver against its strategic goals to acquire, invest in, or enter joint ventures with promising complementary companies to expedite their development and time-to-market. We look to the future with renewed confidence and enthusiasm.”
BSF listed in London in 2019. It’s share price reached a peak in December of that year and has since fallen more than 90%, valued at the time of writing at 1.32p.